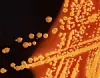
Her ses en koloni af e. coli-bakterier. Et smukt sym, hvsi man spørger to forskere fra Københavns Universitet. Foto: Scanpix

Forskere: Frygtet bakterie er slet ikke så slem
To forskere forsøger i et indlæg at rette lidt op på e. coli-bakteriernes renommé.
“E. coli er ikke bare en lortebakterie”
Sådan lyder overskriften på et indlæg på Videnskab.dk fra to forskere fra Københavns Universitet. De to forskere, lektor Sine Lo Svenningsen og cand.scient Katrine Faxøe Nannestad, kommer i artiklen med et forsvarsskrift for bakterierne, der i offentligheden oftest forbindes med – netop – lort.
E. coli-bakterier er nemlig langt fra bare noget, der kan give dig en slem infektion, hvis du spiser mad fra et uhygiejnisk køkken, eller sætte vandværker i alarmberedskab og gøre drikkevandet udrikkeligt.
– I laboratorier verden over har bakterien E. coli en helt anden status end lortebakterie. Den kommer godt nok fra lort – men hvilket vidunder, skriver Sine Lo Svenningsen og Katrine Faxøe Nannestad og konstaterer, at:
– E. coli var den arbejdshest, som muliggjorde den molekylærbiologiske revolution, vi har oplevet i de sidste 70 år, og som har givet os svaret på mange af grundforskningens store spørgsmål om, hvordan liv, som vi kender det, helt fundamentalt lader sig gøre.
E. coli har nemlig nogle egenskaber, der gør den helt specielt godt egnet til at bruge til forskning. Det var blandt e. coli-DNA, der første gang blev brugt til at knække livets kode og forstå det molekylære alfabet i DNA, lyder et af forskernes argumenter for, hvorfor vi skal være taknemmelige over e. coli-bakterier.
De pointerer også, at E. coli-bakterier fakstisk bliver brugt i en lang række produkter, vi bruger i dagligdagen. Bakterierne bruges nemlig i industrien til at lave proteiner og kemikalier til blandt andet kosmetik, fødevareingredienser, plastikprodukter og medicin.
De to forskere beskriver også et projekt, hvor de selv har brugt e. coli. Du kan læse flere detaljer i deres indlæg her.












